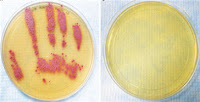

|
| Littlest Pride J.Foster 2008 |
Lesbian's health risks can differ from heterosexual women.
Would you ever ask a heterosexual woman when she 'came out' as heterosexual?
Sexual minorities have barriers to health. These include: discrimination, presumed heterosexism, lack of inclusivity in environment/language/forms.
ENVIRONMENT
FORMS When a Lesbian woman sits in a waiting room, surrounded by images of happy (heterosexual) couples, the visual impact is not inclusive. When her first visit form gives her the option of "Single"; "Married"; "Divorced" "Widowed."What are her choices? She can leave it blank (and be treated as single, even if this is not accurate.) She can check off married as she has been in a monogamous relationship for 20 years. More likely than not, if she opts for the latter, the health care provider in their perusal of the form will say: "So what does your husband do?" So now - she comes out and risks a distancing response by the clinician or she is forced to create a story that colludes with presumed heterosexuality. Creating a condition that forces lack of authenticate communication is not the best start to a clinical relationship.
MORE THAN YOU So you may be saying that you are hip to inclusive language (who helps you? who all lives at home with you? Who do I need to include in your care and what connection are they to you?) But it is more than you. You may terrific, warm, sensitive and inclusive - but they have to get to you. So part of being a responsible clinician is being responsible for oversight of your environment. Snickers or disrespectful treatment of patients by staff have to be addressed and potentially in-service/staff trainings on quality care delivery need to include LGBT issues.
MISPERCEPTION OF RISKS BY PATIENTS AND CLINICIANS
PATIENT CENTERED Lesbian women may not be accurate in assessing their health risks. For example, despite statistics that most lesbian women (2/3-3/4) have had sexual intercourse with men (and therefore have similar risks to heterosexual women.) Many Lesbians feel that they have minimal risk for STIs and for screening studies. Thus, they don't come into care for regular preventive visits.
INVISIBILITY Clinicians might 'miss' risks if they don't know that the woman is a Lesbian. Unclear many other minorities with whom the visual at least generates a question, Lesbian women look like heterosexual women. Additionally, they may feel that it is none of our business (their sexuality) and not include it in their health information. Assessing a support structure is essential when dealing with health issues (who will take to the test? who else should be in the room to hear this in order to reinforce/ decode/support you?) Thus understanding the context of a patient's world and who they are and identify as is important if our goal is excellent care for all.
SPECIFIC HEALTH CONDITIONS AT HIGHER RISK Health specific conditions of note include cancer, cardiovascular disease (as a result of suboptimal weight and smoking), delay in health screening, Breast cancer (both from higher risk factors and fewer screenings), depression, anxiety, smoking, heart disease, uterine cancer, obesity (and therefore obesity related cardiovascular disease), alcohol abuse They may be at higher risk of unabated estrogen related cancers if they are nulliparous (uterine, breast, etc.)
SEXUAL HEALTH PRINCIPLES Remember that there are three important domains to consider when understanding sexual health: orientation, identity and behavior. Orientation: to whom do I gravitate to/ sexual attracted to; Identity: who do I say I identify as; Behavior: what exactly do I do and with whom. We've discussed how these three elements are not concordant (a patient - can have an orientation but not identify as such;can have an identity but not have concordant behavior; can have a behavior but not feel that this relates to identity) There is an arcane term of sexual preference which many people in the non-health arena inaccurately use interchangebly or substitute for orientation. Orientation of sexuality for all people (and creatures) has an neural basis, so it is the preferred medical description. Preference implies that behavior is rather capricious (e.g. I'd like strawberry ice cream, no, vanilla.) We are all socialized in a heterosexual environment. I have yet to meet a person who wants to have discrimination or barriers.
QUICK SAFE SEX TIPS: HPV is a STI (as well as Chlamydia) that is found among women who have sex with women. So first, we need to advise women to wash up (as is true actually with everyone!). Hand washing is important in safe sex. Cleaning sex toys or using condoms and/or dental dams is also important. Lastly, getting regular health maintanence visits to be promote wellness is important. There are a number of resources for Lesbians to identify high quality respectful clinicians. Some cities have Rainbow Health Pages; resources can also be found on the Internet. There are national groups that promote Lesbian Health like our friends at UCSF Lesbian Health & Research Center
Updating our discussion on health issues for women who are lesbians, here's some additional resources.
JAMA September article mentioned - across the U.S. in med schools the coverage is low and variable in nature.
 The Health of Lesbian, Gay, Bisexual, and Transgender People: Building a Foundation for Better Understanding Institute of Medicine 2011 Report available here
The Health of Lesbian, Gay, Bisexual, and Transgender People: Building a Foundation for Better Understanding Institute of Medicine 2011 Report available here
Other web resources:
Gay and Lesbian Medical Association: http://www.glma.org/
Gay Mens Health Crisis (GMHC): http://www.gmhc.org/
CDC Gay and Bisexual Mens Health: http://www.cdc.gov/msmhealth/http://www.cdc.gov/msmhealth/
Lesbian Health and Research Center (UCSF): http://www.lesbianhealthinfo.org/http://www.lesbianhealthinfo.org/
LGBT Aging Project http://www.lgbtagingproject.org/
Lesbian and Bisexual Women’s Health Fact sheets (DHHS): http://www.womenshealth.gov/
American Public Health Association LGBT Initiatives (APHA): http://www.apha.org/about/Public+Health+Links/LinksGayandLesbianHealth.htm
Gay and Lesbian Advocates and Defenders http://www.glad.org/
New England Legal Advocates (lists laws and topics by state)
Makadon H. Improving health care for the lesbian and gay communities. New England Journal of Medicine 2006, Vol. 354 (No. 9), pp. 895-7.
Coker TR, Austin SB, Schuster MA. The health and health care of lesbian, gay, and bisexual adolescents. Annual Review of Public Health 2010. Vol. 31. pp 457-77.
Coren JS, Coren CM, Pagliaro N, Weiss LB. Assessing your office for care of lesbian, gay, bisexual, and transgender patients. Health Care Manager 2011. Vol 30 (No. 1), pp 66-70.
Dowshen N, Garafalo R. Optimizing primary care for LGBTQ youth. Contemporary Pediatrics, October 2009, pp. 58-65.
Kann L, Olsen EO, McManus T et al. Sexual Identity, Sex of Sexual Contact, Health-Risk Behaviors Among Students Grades 9-12 – Youth Risk Behavior Surveillance, Selected Sites, United States, 2001-2009. MMWR, June 10, 2011, Vol 60, No. 7.
Katz K. Health Hazards of “Don’t Ask, Don’t Tell”. New England Journal of Medicine 2010. Vol 363 (No. 12), pp 2380-1.

0 comments:
Post a Comment